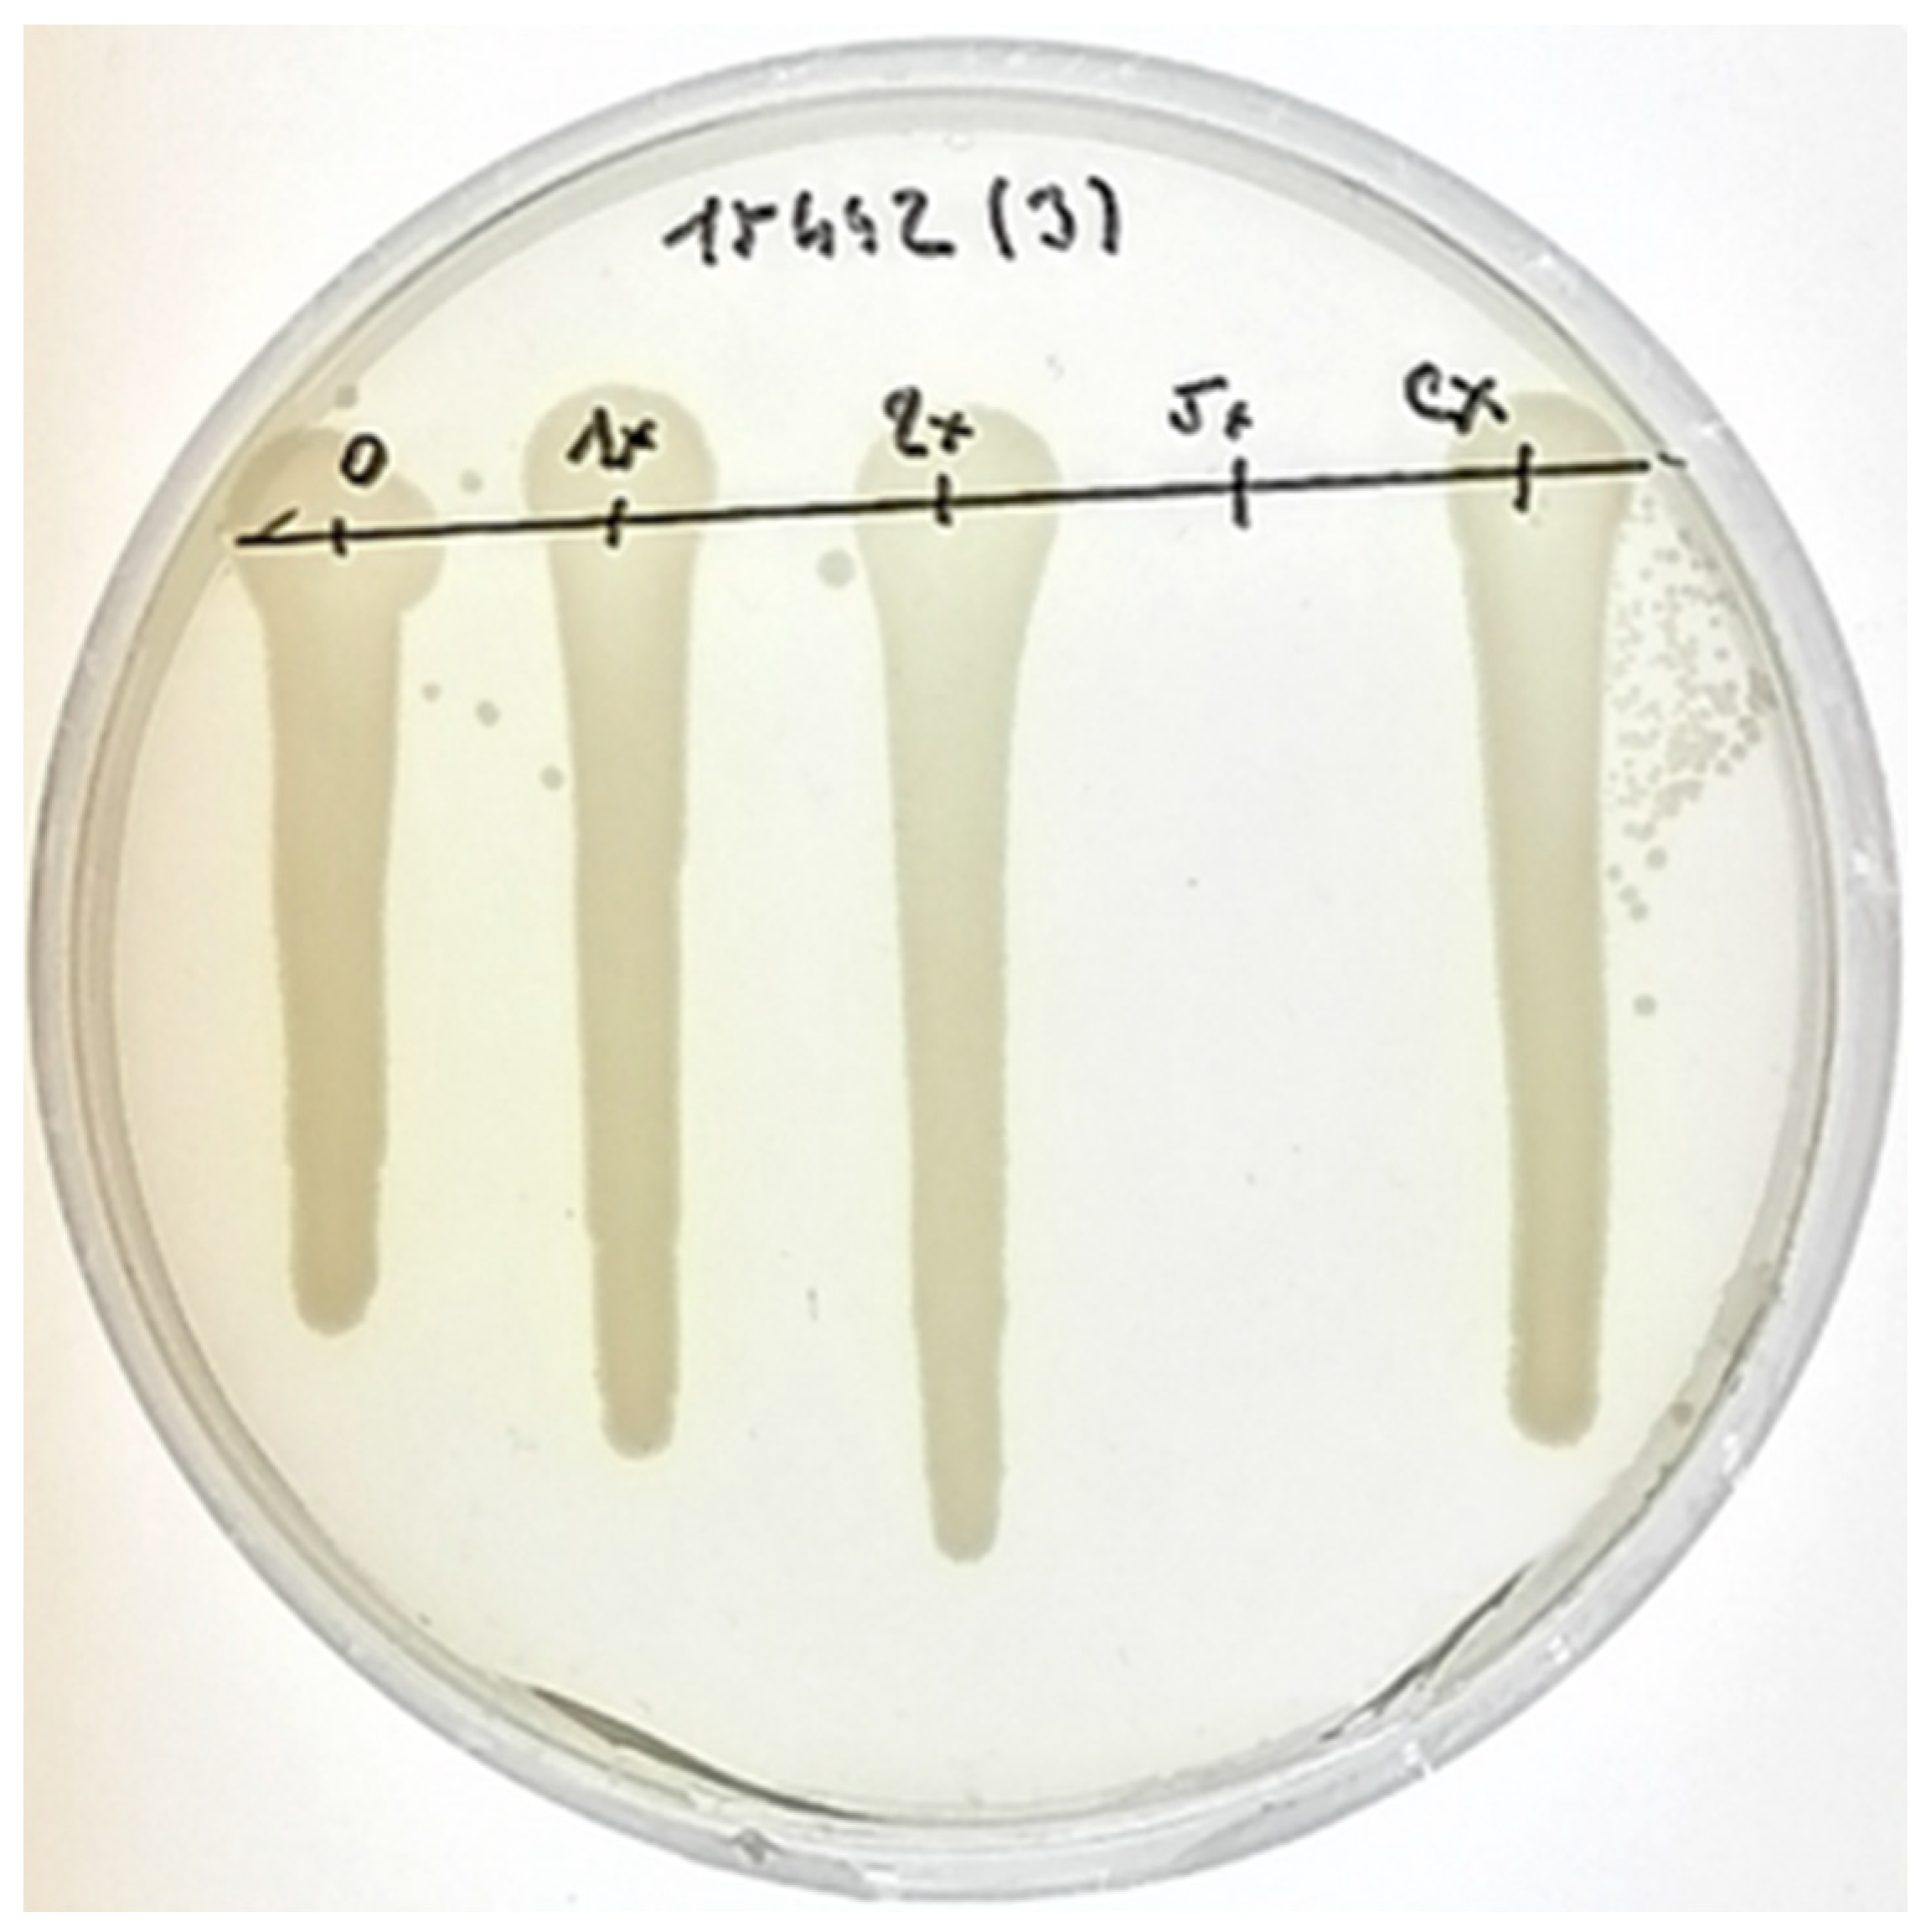
Plants 11 00443 g004 550

Silver Nanoparticle Production Mediated by Vitis vinifera Cane Extract: Characterization and Antibacterial Activity Evaluation
Abstract
:1. Introduction
2. Results
2.1. Nanoparticle Biosynthesis and Characterization
2.2. Minimal Inhibition Concentration of AgNPs against Planktonic Cells of P. aeruginosa
2.3. Bactericidal Activity of AgNPs against P. aeruginosa Cells
2.4. Biological Activity of AgNPs against Adhering Cells of P. aeruginosa
3. Discussion
4. Materials and Methods
4.1. Materials for Biosynthesis
4.2. Extraction Method
4.3. Green Synthesis of Silver Nanoparticles
4.4. Characterization of Nanoparticles
4.5. Microbial Strains and Growth Media
4.6. Evaluation of Minimal Inhibitory Concentration (MIC)
4.7. Evaluation of Minimal Bactericidal Concentration (MBC)
4.8. Evaluation of Minimal Biofilm Inhibitory Concentration (MBIC)
4.8.1. Cultivation Conditions
4.8.2. MTT Assay
4.9. Statistical Analysis
5. Conclusions
Author Contributions
Funding
Institutional Review Board Statement
Informed Consent Statement
Data Availability Statement
Acknowledgments
Conflicts of Interest
References
- Thakkar, K.N.; Mhatre, S.S.; Parikh, R.Y. Biological synthesis of metallic nanoparticles. Nanomed. Nanotechnol. Biol. Med. 2010, 6, 257–262. [Google Scholar] [CrossRef] [PubMed]
- Baptista, P.V.; McCusker, M.P.; Carvalho, A.; Ferreira, D.A.; Mohan, N.M.; Martins, M.; Fernandes, A.R. Nano-Strategies to Fight Multidrug Resistant Bacteria—“A Battle of the Titans”. Front. Microbiol. 2018, 9, 1441. [Google Scholar] [CrossRef] [Green Version]
- Kulkarni, N.; Muddapur, U. Biosynthesis of Metal Nanoparticles: A Review. J. Nanotechnol. 2014, 354, 1–8. [Google Scholar] [CrossRef] [Green Version]
- El-Seedi, H.R.; El-Shabasy, R.M.; Khalifa, S.A.M.; Saeed, A.; Shah, A.; Shah, R.; Iftikhar, F.J.; Abdel-Daim, M.M.; Omri, A.; Hajrahand, N.H.; et al. Metal nanoparticles fabricated by green chemistry using natural extracts: Biosynthesis, mechanisms, and applications. RSC Adv. 2019, 9, 24539–24559. [Google Scholar] [CrossRef] [Green Version]
- Shameli, K.; Bin Ahmad, M.; Jaffar Al-Mulla, E.A.; Ibrahim, N.A.; Shabanzadeh, P.; Rustaiyan, A.; Abdollahi, Y.; Bagheri, S.; Abdolmohammadi, S.; Usman, M.S.; et al. Green biosynthesis of silver nanoparticles using Callicarpa maingayi stem bark extraction. Molecules 2012, 17, 8506–8517. [Google Scholar] [CrossRef] [PubMed]
- Amini, S.M. Preparation of antimicrobial metallic nanoparticles with bioactive compounds. Mater. Sci. Eng. C 2019, 103, 109809. [Google Scholar] [CrossRef] [PubMed]
- Anshup, A.; Venkataraman, J.S.; Subramaniam, C.; Kumar, R.R.; Priya, S.; Kumar, T.R.S.; Omkumar, R.V.; John, A.; Pradeep, T. Growth of gold nanoparticles in human cells. Langmuir 2005, 21, 11562–11567. [Google Scholar] [CrossRef] [PubMed]
- Kowshik, M.; Deshmukh, N.; Vogel, W.; Urban, J.; Kulkarni, S.K.; Paknikar, K.M. Microbial synthesis of semiconductor CdS nanoparticles, their characterization, and their use in the fabrication of an ideal diode. Biotechnol. Bioeng. 2002, 78, 583–588. [Google Scholar] [CrossRef] [PubMed]
- Lengke, M.F.; Fleet, M.E.; Southam, G. Biosynthesis of silver nanoparticles by filamentous cyanobacteria from a silver(I) nitrate complex. Langmuir 2007, 23, 2694–2699. [Google Scholar] [CrossRef]
- Parveen, K.; Banse, V.; Ledwani, L. Green synthesis of nanoparticles: Their advantages and disadvantages. In AIP Conference Proceedings; AIP Publishing LLC.: Melville, NY, USA, 2016; p. 020048. [Google Scholar]
- Rautaray, D.; Ahmad, A.; Sastry, M. Biosynthesis of CaCO3 Crystals of Complex Morphology Using a Fungus and an Actinomycete. J. Am. Chem. Soc. 2003, 125, 14656–14657. [Google Scholar] [CrossRef]
- Shahverdi, A.R.; Minaeian, S.; Shahverdi, H.R.; Jamalifar, H.; Nohi, A.-A. Rapid synthesis of silver nanoparticles using culture supernatants of Enterobacteria: A novel biological approach. Processes Biochem. 2007, 42, 919–923. [Google Scholar] [CrossRef]
- Raheman, F.; Deshmukh, S.; Ingle, A.; Gade, A.; Rai, M. Silver Nanoparticles: Novel Antimicrobial Agent Synthesized from an Endophytic Fungus Pestalotia sp. Isolated from leaves of Syzygium cumini (L). Nano Biomed. Eng. 2011, 3, 174–178. [Google Scholar] [CrossRef]
- Sunkar, S.; Nachiyar, C.V. Biogenesis of antibacterial silver nanoparticles using the endophytic bacterium Bacillus cereus isolated from Garcinia xanthochymus. Asian Pac. J. Trop. Biomed. 2012, 2, 953–959. [Google Scholar] [CrossRef] [Green Version]
- Kora, A.J.; Sashidhar, R.B.; Arunachalam, J. Aqueous extract of gum olibanum (Boswellia serrata): A reductant and stabilizer for the biosynthesis of antibacterial silver nanoparticles. Processes Biochem. 2012, 47, 1516–1520. [Google Scholar] [CrossRef]
- Chandran, K.; Song, S.; Yun, S.-I. Effect of size and shape controlled biogenic synthesis of gold nanoparticles and their mode of interactions against food borne bacterial pathogens. Arab. J. Chem. 2014, 12, 1994–2006. [Google Scholar] [CrossRef] [Green Version]
- Raut, R.W.; Mendhulkar, V.D.; Kashid, S.B. Photosensitized synthesis of silver nanoparticles using Withania somnifera leaf powder and silver nitrate. J. Photochem. Photobiol. B Biol. 2014, 132, 45–55. [Google Scholar] [CrossRef] [PubMed]
- Sathishkumar, M.; Sneha, K.; Won, S.W.; Cho, C.W.; Kim, S.; Yun, Y.S. Cinnamon zeylanicum bark extract and powder mediated green synthesis of nano-crystalline silver particles and its bactericidal activity. Colloids Surf. B Biointerfaces 2009, 73, 332–338. [Google Scholar] [CrossRef]
- Gnanajobitha, G.; Paulkumar, K.; Vanaja, M.; Rajeshkumar, S.; Malarkodi, C.; Annadurai, G.; Kannan, C. Fruit-mediated synthesis of silver nanoparticles using Vitis vinifera and evaluation of their antimicrobial efficacy. J. Nanostructure Chem. 2013, 3, 67. [Google Scholar] [CrossRef] [Green Version]
- Saratale, R.G.; Saratale, G.D.; Ahn, S.; Shin, H.-S. Grape Pomace Extracted Tannin for Green Synthesis of Silver Nanoparticles: Assessment of Their Antidiabetic, Antioxidant Potential and Antimicrobial Activity. Polymers 2021, 13, 4355. [Google Scholar] [CrossRef]
- Kuppusamy, P.; Yusoff, M.M.; Maniam, G.P.; Govindan, N. Biosynthesis of metallic nanoparticles using plant derivatives and their new avenues in pharmacological applications—An updated report. Saudi Pharm. J. 2016, 24, 473–484. [Google Scholar] [CrossRef]
- Jacobs, C.; Kayser, O.; Müller, R.H. Nanosuspensions as a new approach for the formulation for the poorly soluble drug tarazepide. Int. J. Pharm. 2000, 196, 161–164. [Google Scholar] [CrossRef]
- Aruguete, D.M.; Kim, B.; Hochella, M.F.; Ma, Y.; Cheng, Y.; Hoegh, A.; Liu, J.; Pruden, A. Antimicrobial nanotechnology: Its potential for the effective management of microbial drug resistance and implications for research needs in microbial nanotoxicology. Environ. Sci. Process. Impacts 2012, 15, 93–102. [Google Scholar] [CrossRef] [PubMed]
- Makarov, V.V.; Love, A.J.; Sinitsyna, O.V.; Makarova, S.S.; Yaminsky, I.V.; Taliansky, M.E.; Kalinina, N.O. “Green” nanotechnologies: Synthesis of metal nanoparticles using plants. Acta Nat. 2014, 6, 95. [Google Scholar] [CrossRef] [Green Version]
- Packialakshmi, N.; Naziya, S. Green Synthesis of Silver Nanoparticles from Stem Extracts of Caralluma Fimbriyata and Its Antibacterial Activity. Int. J. Appl. Sci. Biotechnol. 2014, 2, 305–310. [Google Scholar] [CrossRef] [Green Version]
- Bharathi, D.; Diviya Josebin, M.; Vasantharaj, S.; Bhuvaneshwari, V. Biosynthesis of silver nanoparticles using stem bark extracts of Diospyros montana and their antioxidant and antibacterial activities. J. Nanostruct. Chem. 2018, 8, 83–92. [Google Scholar] [CrossRef] [Green Version]
- Haiss, W.; Thanh, N.T.K.; Aveyard, J.; Fernig, D.G. Determination of Size and Concentration of Gold Nanoparticles from UV−Vis Spectra. Anal. Chem. 2007, 79, 4215–4221. [Google Scholar] [CrossRef]
- Nayak, D.; Ashe, S.; Rauta, P.R.; Kumari, M.; Nayak, B. Bark extract mediated green synthesis of silver nanoparticles: Evaluation of antimicrobial activity and antiproliferative response against osteosarcoma. Mater. Sci. Eng. C 2016, 58, 44–52. [Google Scholar] [CrossRef]
- Rao, B.; Tang, R.-C. Green synthesis of silver nanoparticles with antibacterial activities using aqueous Eriobotrya japonica leaf extract. Adv. Nat. Sci. Nanosci. Nanotechnol. 2017, 8, 015014. [Google Scholar] [CrossRef] [Green Version]
- Ravichandran, V.; Vasanthi, S.; Shalini, S.; Ali Shah, S.A.; Harish, R. Green synthesis of silver nanoparticles using Atrocarpus altilis leaf extract and the study of their antimicrobial and antioxidant activity. Mater. Lett. 2016, 180, 264–267. [Google Scholar] [CrossRef]
- Anandalakshmi, K.; Venugobal, J.; Ramasamy, V. Characterization of silver nanoparticles by green synthesis method using Pedalium murex leaf extract and their antibacterial activity. Appl. Nanosci. 2016, 6, 399–408. [Google Scholar] [CrossRef] [Green Version]
- Singh, P.; Pandit, S.; Garnæs, J.; Tunjic, S.; Mokkapati, V.R.S.S.; Sultan, A.; Thygesen, A.; Mackevica, A.; Mateiu, R.V.; Daugaard, A.E.; et al. Green synthesis of gold and silver nanoparticles from Cannabis sativa (industrial hemp) and their capacity for biofilm inhibition. Int. J. Nanomed. 2018, 13, 3571–3591. [Google Scholar] [CrossRef] [PubMed]
- Sadeghi, B.; Gholamhoseinpoor, F. A study on the stability and green synthesis of silver nanoparticles using Ziziphora tenuior (Zt) extract at room temperature. Spectrochim. Acta Part A Mol. Biomol. Spectrosc. 2015, 134, 310–315. [Google Scholar] [CrossRef] [PubMed]
- Ahmed, S.; Saifullah; Ahmad, M.; Swami, B.L.; Ikram, S. Green synthesis of silver nanoparticles using Azadirachta indica aqueous leaf extract. J. Radiat. Res. Appl. Sci. 2016, 9, 1–7. [Google Scholar] [CrossRef] [Green Version]
- Vijayakumar, A.S. Pharmacological activity of silver nanoparticles, ethanolic extract from justicia gendarussa (burm) f plant leaves. Res. J. Life Sci. Bioinform. Pharm. Chem. Sci. 2019, 5, 462–475. [Google Scholar] [CrossRef]
- Deshmukh, S.P.; Patil, S.M.; Mullani, S.B.; Delekar, S.D. Silver nanoparticles as an effective disinfectant: A review. Mater. Sci. Eng. C 2019, 97, 954–965. [Google Scholar] [CrossRef]
- Vaňková, E.; Paldrychová, M.; Kašparová, P.; Lokočová, K.; Kodeš, Z.; Maťátková, O.; Kolouchová, I.; Masák, J. Natural antioxidant pterostilbene as an effective antibiofilm agent, particularly for gram-positive cocci. World J. Microbiol. Biotechnol. 2020, 36, 101. [Google Scholar] [CrossRef]
- Pompilio, A.; Geminiani, C.; Bosco, D.; Rana, R.; Aceto, A.; Bucciarelli, T.; Scotti, L.; Di Bonaventura, G. Electrochemically Synthesized Silver Nanoparticles Are Active Against Planktonic and Biofilm Cells of Pseudomonas aeruginosa and Other Cystic Fibrosis-Associated Bacterial Pathogens. Front. Microbiol. 2018, 9, 1349. [Google Scholar] [CrossRef] [Green Version]
- Singh, K.; Panghal, M.; Kadyan, S.; Chaudhary, U.; Yadav, J.P. Green silver nanoparticles of Phyllanthus amarus: As an antibacterial agent against multi drug resistant clinical isolates of Pseudomonas aeruginosa. J. Nanobiotechnol. 2014, 12, 40. [Google Scholar] [CrossRef] [Green Version]
- Radzig, M.; Koksharova, O.; Khmel, I.A. Antibacterial effects of silver ions: Effect on gram-negative bacteria growth and biofilm formation. Mol. Gen. Mikrobiol. Virusol 2009, 24, 194–199. [Google Scholar] [CrossRef]
- Palanisamy, N.K.; Ferina, N.; Amirulhusni, A.N.; Mohd-Zain, Z.; Hussaini, J.; Ping, L.J.; Durairaj, R. Antibiofilm properties of chemically synthesized silver nanoparticles found against Pseudomonas aeruginosa. J. Nanobiotechnol. 2014, 12, 2. [Google Scholar] [CrossRef] [Green Version]
- Markowska, K.; Grudniak, A.M.; Krawczyk, K.; Wróbel, I.; Wolska, K.I. Modulation of antibiotic resistance and induction of a stress response in Pseudomonas aeruginosa by silver nanoparticles. J. Med. Microbiol. 2014, 63, 849–854. [Google Scholar] [CrossRef] [PubMed] [Green Version]
- Lara, H.; Ayala-Nunez, V.; Ixtepan Turrent, L.; Rodríguez-Padilla, C. Bactericidal effect of AgNPs against multidrug-resistant bacteria. World J. Microbiol. Biotechnol. 2009, 26, 615–621. [Google Scholar] [CrossRef]
- Mohan, S.; Oluwafemi, O.S.; George, S.C.; Jayachandran, V.P.; Lewu, F.B.; Songca, S.P.; Kalarikkal, N.; Thomas, S. Completely green synthesis of dextrose reduced silver nanoparticles, its antimicrobial and sensing properties. Carbohydr. Polym. 2014, 106, 469–474. [Google Scholar] [CrossRef] [PubMed]
- Rollová, M.; Gharwalova, L.; Krmela, A.; Schulzová, V.; Hajšlová, J.; Jaroš, P.; Kolouchová, I.; Maťátková, O. Grapevine extracts and their effect on selected gut-associated microbiota: In vitro study. Czech. J. Food Sci. 2020, 38, 137–143. [Google Scholar] [CrossRef]
- Sharma, M.; Manoharlal, R.; Negi, A.S.; Prasad, R. Synergistic anticandidal activity of pure polyphenol curcumin I in combination with azoles and polyenes generates reactive oxygen species leading to apoptosis. FEMS Yeast Res. 2010, 10, 570–578. [Google Scholar] [CrossRef]
- Serra, E.; Hidalgo-Bastida, L.A.; Verran, J.; Williams, D.; Malic, S. Antifungal Activity of Commercial Essential Oils and Biocides against Candida albicans. Pathogens 2018, 7, 15. [Google Scholar] [CrossRef] [Green Version]
- Rahal, J.J.; Simberkoff, M.S. Bactericidal and Bacteriostatic Action of Chloramphenicol Against Meningeal Pathogens. Antimicrob. Agents Chemother. 1979, 16, 13–18. [Google Scholar] [CrossRef] [Green Version]
- Shin, D.-S.; Eom, Y.-B. Zerumbone inhibits Candida albicans biofilm formation and hyphal growth. Can. J. Microbiol. 2019, 65, 713–721. [Google Scholar] [CrossRef]
- Sabaeifard, P.; Abdi-Ali, A.; Soudi, M.R.; Dinarvand, R. Optimization of tetrazolium salt assay for Pseudomonas aeruginosa biofilm using microtiter plate method. J. Microbiol. Methods 2014, 105, 134–140. [Google Scholar] [CrossRef]

| Zeta Potential (mV) | Z-Average (d nm) | Polydispersity Index |
|---|---|---|
| –30.4 ± 3.88 | 68.18 ± 2.65 | 0.214 |
| Pseudomonas aeruginosa Strain | PAO1 | ATCC 10145 | ATCC 15442 | DBM 3081 | DBM 3777 |
|---|---|---|---|---|---|
| MIC80 (% v/v) | 1.88 | 1.88 | 2.50 | 3.13 | 3.13 |
| Pseudomonas aeruginosa Strain | PAO1 | ATCC 10145 | ATCC 15442 | DBM 3081 | DBM 3777 |
|---|---|---|---|---|---|
| MBC (% v/v) | 10.71 | - | 12.50 | 15.63 | 15.63 |
| Pseudomonas aeruginosa Strain | PAO1 | ATCC 10145 | ATCC 15442 | DBM 3081 | DBM 3777 |
|---|---|---|---|---|---|
| MBIC50 (% v/v) | <3.93 | 5.00 | <5.36 | 3.21 | - |
| MBIC90 (% v/v) | 3.93 | - | 5.36 | 5.36 | - |
Publisher’s Note: MDPI stays neutral with regard to jurisdictional claims in published maps and institutional affiliations. |
© 2022 by the authors. Licensee MDPI, Basel, Switzerland. This article is an open access article distributed under the terms and conditions of the Creative Commons Attribution (CC BY) license (https://creativecommons.org/licenses/by/4.0/).
Share and Cite
Michailidu, J.; Maťátková, O.; Kolouchová, I.; Masák, J.; Čejková, A. Silver Nanoparticle Production Mediated by Vitis vinifera Cane Extract: Characterization and Antibacterial Activity Evaluation. Plants 2022, 11, 443. https://doi.org/10.3390/plants11030443
Michailidu J, Maťátková O, Kolouchová I, Masák J, Čejková A. Silver Nanoparticle Production Mediated by Vitis vinifera Cane Extract: Characterization and Antibacterial Activity Evaluation. Plants. 2022; 11(3):443. https://doi.org/10.3390/plants11030443
Chicago/Turabian StyleMichailidu, Jana, Olga Maťátková, Irena Kolouchová, Jan Masák, and Alena Čejková. 2022. "Silver Nanoparticle Production Mediated by Vitis vinifera Cane Extract: Characterization and Antibacterial Activity Evaluation" Plants 11, no. 3: 443. https://doi.org/10.3390/plants11030443
APA StyleMichailidu, J., Maťátková, O., Kolouchová, I., Masák, J., & Čejková, A. (2022). Silver Nanoparticle Production Mediated by Vitis vinifera Cane Extract: Characterization and Antibacterial Activity Evaluation. Plants, 11(3), 443. https://doi.org/10.3390/plants11030443

